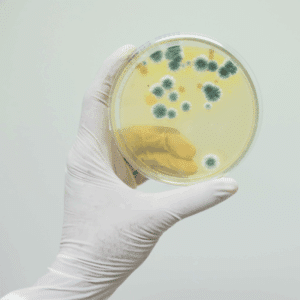
Mold spores under magnification

Mold Cleanup and Water Damage Restoration You Can Trust in Ogden, Utah
When water damage strikes - whether from a roof leak, burst pipe, or flooding - the clock starts ticking. In less than 24 hours, mold can begin to grow in damp areas of your home. Left untreated, it spreads fast, threatening both your property and your health. At Utah Flood Cleanup, we provide expert water damage and mold remediation across Ogden, Salt Lake City, and nearby Utah communities.
Certified. Local. Trusted for over a decade.
Donโt wait until the damage gets worse - call now for help.
What Our Customers Say
Why Ignoring Mold Costs More Than You Think
Water damage is stressful enough. But when mold sets in, it becomes a much bigger problem. Mold often begins within 24โ48 hours of water exposure. It spreads behind walls, under carpets, and into HVAC systems. The longer it goes untreated, the harder and more expensive it becomes to remove.
More importantly, mold is a biohazard. It can trigger asthma, allergies, and long-term respiratory problems, especially in children and older adults. And because it feeds on organic material, mold will quietly destroy structural supports, furniture, and walls if left unchecked.
What this really means is simple: if you see or suspect mold, waiting isnโt an option.
What is Mold?
Mold spreads by airborne spores and can appear in many colors: white, green, brown, pink, orange, or black. Black mold is often feared as the most dangerous, but the truth is that many molds can produce toxins in the right conditions. Mold also gives off a damp, musty odor - one of the first warning signs of its presence.
While mold plays a vital role outdoors by decomposing organic matter, you donโt want it decomposing the studs and beams that hold your house together.
Common areas to check for mold growth include:
- The basement
- Under sinks
- Around doors and windows
- Bathrooms
- Attics
- Behind walls and ceilings
- Near plumbing lines
- Under furniture
Tip: Always use exhaust fans in kitchens and bathrooms to reduce moisture buildup.
Why Does Water Damage Always Cause Mold?
If your home floods due to a roof leak, burst pipe, ice damming, or appliance failure, mold is almost guaranteed to follow unless quick action is taken. Mold only needs three things to thrive:
- Sugar or starch (food source)
- Oxygen
- Moisture
Moisture is the variable you can control. Without proper drying, mold will continue to spread year-round, whether itโs hot or cold outside.
Is Mold Hazardous?
Yes. Mold is dangerous to both your health and your home. Spores can travel through the air and circulate via your HVAC system, spreading the infestation throughout the entire property.
Health Risks of Mold Exposure:
- Chronic coughing or wheezing
- Sneezing, eye irritation, hay fever-like symptoms
- Breathing difficulties
- Severe respiratory reactions in children and the elderly
- Headaches
- Fatigue
For those with allergies or long-term exposure, the effects can be much more serious.
Structural Risks of Mold:
Mold consumes organic materials like drywall, insulation, and wood beams. Over time, untreated infestations can weaken the structure of your home.
How to Stop Mold from Water Damage
If water intrusion occurs in your home, quick action is the only way to prevent mold.
Hereโs what to do immediately:
- Shut off your homeโs main water valve.
- Open windows for ventilation.
- Turn on all fans and dehumidifiers.
- Remove affected furniture and carpet.
- Document the damage with photos for insurance.
Then, call professionals to:
- Perform a complete mold inspection (attics, behind walls, insulation, plumbing lines).
- Use industrial drying equipment for hidden structures.
- Complete professional mold remediation to eliminate spores and prevent regrowth.
Our Solutions and Benefits
โ๏ธ Certified Mold Experts
IICRC-certified specialists trained in water and mold restoration.
โ๏ธ Rapid 24/7 Response
Weโre on call day or night, because mold doesnโt wait.
โ๏ธ Insurance Direct Billing
We work directly with your insurance company, easing your stress.
โ๏ธ Safe, Lasting Results
We donโt just remove visible mold - we restore your property fully.
Why Choose Utah Flood Cleanup
Trusted Across Ogden, Salt Lake City, and Northern Utah
- Over 10 years of proven experience
- IICRC Certified Team
- Free phone consultations and free inspections for covered events
- Service warranties and satisfaction guarantees
- 5-star reviews from Utah homeowners
When you choose Utah Flood Cleanup, youโre choosing local professionals who know how to get it done right.
Our Core Services
- Flood Cleanup - Remove standing water quickly
- Flood Restoration - Repair and restore damaged areas
- Water Damage Restoration - Full structural drying and repair
- Fire and Smoke Damage Cleanup - Eliminate damage and odors
- Mold Damage Restoration - Identify, remove, and prevent mold growth
All services are available 24/7 across Ogden, Salt Lake City, and the surrounding Utah communities.
Frequently Asked Questions
Is all mold dangerous?
Not all mold is toxic, but any mold can damage property and impact health. For severe cases, see our black mold remediation guidance.
Can I handle mold cleanup myself?
Small surface mold may be manageable, but hidden mold always requires professionals.
Does water damage always cause mold?
Not always, but the risk is very high without proper drying.
What areas do you serve?
We proudly serve Ogden, Salt Lake City, and surrounding Northern Utah.
Our Service Area
Proudly Serving Utah Homes and Businesses
Utah Flood Cleanup is based in Ogden and provides full service to
Salt Lake City, Layton, Bountiful, Clearfield, and beyond.
Ready to Get Reliable Mold and Water Damage Restoration?
Proudly serving Ogden, Salt Lake City, and communities across Utah.
Utah Flood Cleanup is here to protect your home, restore your property, and safeguard your familyโs health. Call today and let our experts handle the hard work.